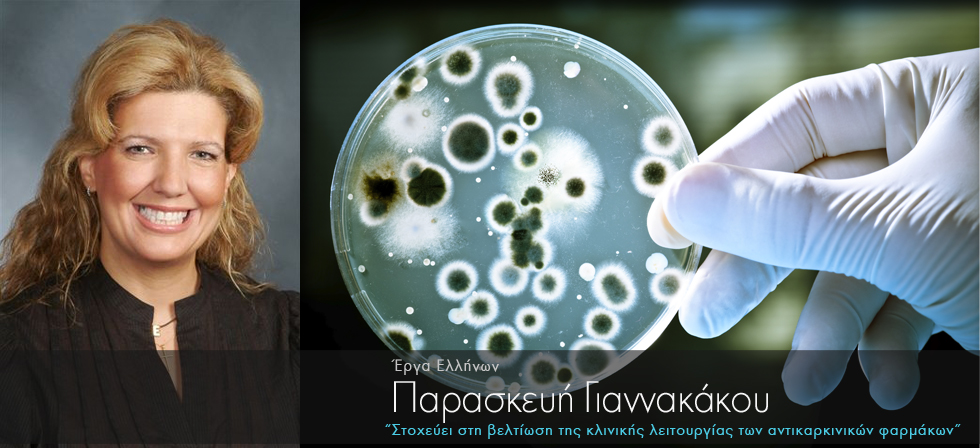
Ελληνίδα βελτιώνει τα φάρμακα για τον καρκίνο

Διαβάστε στο www.ellines.com
Η Παρασκευή Γιαννακάκου είναι βοηθός καθηγήτρια Φαρμακολογίας της Ιατρικής στο Τμήμα Αιματολογίας και Ιατρικής Ογκολογίας στο Weill Cornell Medical College του Πανεπιστημίου Cornell στη Νέα Υόρκη. Η έρευνα της στοχεύει στην εξήγηση και την βελτίωση της κλινικής λειτουργίας των αντικαρκινικών φαρμάκων.
Η Ελληνίδα ερευνήτρια με την ομάδα της προσπαθεί να αναπτύξει μικρορροϊκές συσκευές που συλλαμβάνουν καρκινικά κύτταρα σε ασθενείς με μεταστατικό προστάτη ή καρκίνο του μαστού.
Για τη συνέχεια του άρθρου πατήστε εδώ